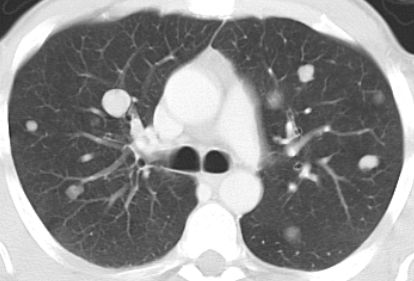

| zurück
Home |
Nebennieren - Rinden - Tumoren |
| allgemeines |
|
Epidemiologie |
Das adrenocorticale Karzinom ist selten. |
0,7-2,0 neue Fälle / 1.000.000 EW*a |
Prognose |
5-a-Survival < 15% bei metastasiertem Karzinom. |
Klinik |
|
Kinder |
Germline TP53-Mutation in 50%-65% |
Brasilien 95% TP53p.R337H-Mutation |
Metastasierung |
Lungenmetastasen nach NNR-Karzinom
 |
Staging |
TNM - Klassifikation nach UICC/AJCC 7 |
Adenom |
 |
 |
69-jährige Frau mit Zervixkarzinom von 6 Monaten. Nach kombinierter Radiotherapie und Chemotherapie rezidivfrei.
Linke Nebenniere vergrößert, KM-aufnehmend. Befund seit 9 Monaten konstant.
 |
Adenom |
79-jähriger berenteter, adipöser Fleischer mit respiratorischer Insuffizienz. Urothel-Ca vor 15 Jahren.
Jetzt kleines Bronchial-Karzinom. Beim Tumorstaging wurde ein großer NN-Tumor rechts entdeckt. |
 |
 |
 |
 |
 |
Diagnostik |
|
Morphologie |
Lin–Weiss–Bisceglia criteria (2,3) |
Zur Unterscheidung von malignen und nicht malignen Oncozytären NNR-Neoplasien |
Therapie |
Chemotherapie |
Mitotane |
Lysodren® |
500mg Tabletten |
| Mitotane-Streptozocin,
Etoposid-Cisplatin-Doxorubicin, Gemcitabine-Capezitabine |
| Ergebnisse |
FIRM-ACT-Studie |
| ACCOMPLISH |
Pembrolizumab plus Lenvatinib in advanced adrenal cortical carcinoma after failure of platinum- and mitotane-based chemotherapy |
| ADUIVO2: Mitotane +- Cisplatin-Etoposid
(Rekrutierung) |
|
Rest |
European Network for the Study of Adrenal Tumors |
Teil von |
Tumoren endokriner Organe |
Onkologie |
| Quellen |
1.) Fassnacht M, Johanssen S, Quinkler M, et al.:
Limited prognostic value of the 2004 International Union Against Cancer
staging classification for adrenocortical carcinoma: proposal for a Revised
TNM Classification.
Cancer 115(2009):243–50
2. Mete O, Gill A, Sasano H:
Adrenal cortical carcinoma. In: WHO classification of tumors: urinary and male genital tumors.
Lyon, France: International Agency for Research on Cancer, 2022.
3. Bisceglia M, Ludovico O, Di Mattia A, et al:.
Adrenocortical oncocytic tumors: report of 10 cases and review of the literature.
Int J Surg Pathol 2004;12:231-43.
|
 |